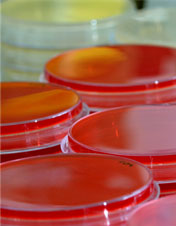

Understand Viruses,
Control the Diseases
ウイルス感染症を理解して制御する
Division of Molecular Virology
Department of Infection Biology
University of Tsukuba
Admission
分子ウイルス学研究室では医学だけでなく多様なバックグラウンドの学生が研究を進めています。
5年一貫制博士課程
ヒューマンバイオロジー学位プログラム
ヒューマニクス学位プログラム
Access
興味がある方は、お気軽に下記にご連絡ください。
筑波大学医学医療系
感染生物学部門 分子ウイルス学分野
〒305-8575
茨城県つくば市天王台一丁目1番1
健康医科学イノベーション棟501
川口 敦史
ats-kawaguchi【at】md.tsukuba.ac.jp
029-853-3233